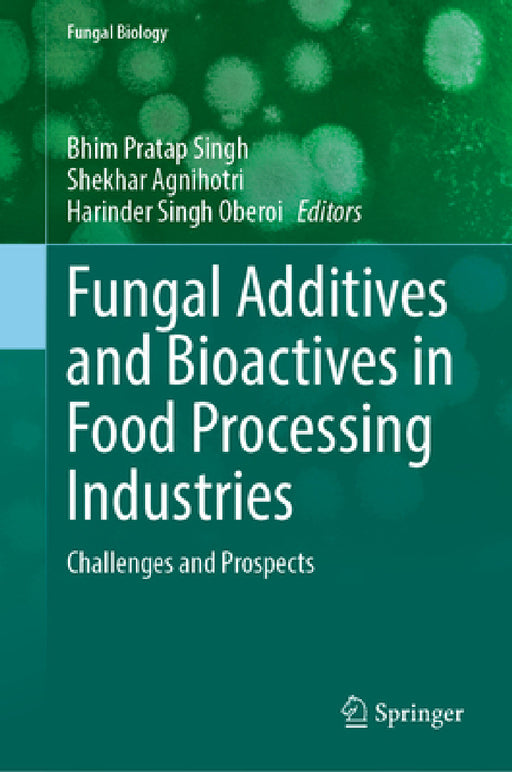
Fungal Additives and Bioactives in Food Processing Industries: Challenges and Prospects by Bhim Pratap Singh, Shekhar Agnihotri, Harinder Singh Oberoi

Springer
Filters
Emotional Appeals in Argumentation: From Rhetoric to Psychology and Artificial Intelligence
Barbara Konat
Hardcover
• Author(s): Barbara Konat • Publisher: Springer • Publisher Imprint: Springer • BISAC: Cognitive ScienceThis book offers an investigation of emotional appeals (pathos) in natural language argumentation. Building on rhetorical theory, psychology,...
View full detailsNew Methods for Measuring Inequality by Analyzing Assortative Mating
Anna Naszodi
Hardcover
• Author(s): Anna Naszodi • Publisher: Springer • Publisher Imprint: Springer • BISAC: Demography
Engineering Educational Games for a Sustainable Society: Play, Learn and Transform
Antonio Bucchiarone, Valentina Rossi, Vanissa Wanick
Hardcover
• Author(s): Antonio Bucchiarone | Valentina Rossi | Vanissa Wanick • Publisher: Springer • Publisher Imprint: Springer • BISAC: Programming - Games
Sustainable Fertilizers: Utilizing Biomass Ashes and Biochars: Transforming Waste Into Agricultural Products
Katarzyna Chojnacka, Filip Gil, Dawid Skrzypczak
Paperback
• Author(s): Katarzyna Chojnacka | Filip Gil | Dawid Skrzypczak • Publisher: Springer • Publisher Imprint: Springer • BISAC: Chemical & BiochemicalThis book provides an in-depth exploration of biomass ashes and biochars as sustainable soil am...
View full detailsEnterprise AI
Shazia Sadiq
Hardcover
• Author(s): Shazia Sadiq • Publisher: Springer • Publisher Imprint: Springer • BISAC: Management Information Systems
Innovation, Resilience, Leadership and Sustainability in Higher Education
Jesús Martín-Vaquero, Luis Hernández-Álvarez, Antonio González Sánchez
Hardcover
• Author(s): Jesús Martín-Vaquero | Luis Hernández-Álvarez | Antonio González Sánchez • Publisher: Springer • Publisher Imprint: Springer • BISAC: Adult & Continuing Education
Set-Valued Approaches to Control and Estimation of Uncertain Systems: Theory and Applications
Thach Ngoc Dinh, Andreas Rauh, Sze Zheng Yong
Hardcover
• Author(s): Thach Ngoc Dinh | Andreas Rauh | Sze Zheng Yong • Publisher: Springer • Publisher Imprint: Springer • BISAC: ElectricalThis edited book presents recent advances in state estimation, robust control synthesis, system identification, fa...
View full detailsMeasurement, Automation, and Control in Artificial Intelligence and Machine Learning
Puramanathan Naidoo, Matthew Sibanda
Hardcover
• Author(s): Puramanathan Naidoo | Matthew Sibanda • Publisher: Springer • Publisher Imprint: Springer • BISAC: ElectricalIntroduction.- Historical Evolution of Process Automation.- IoT in Industrial Process Control.- Machine Learning and AI in A...
View full detailsEmerging Trends in Information Systems and Technologies: Worldcist 2025. Volume 1
Alvaro Rocha, Hojjat Adeli, Aneta Poniszewska-Maranda
Paperback
• Author(s): Alvaro Rocha | Hojjat Adeli | Aneta Poniszewska-Maranda • Publisher: Springer • Publisher Imprint: Springer • BISAC: Artificial Intelligence - GeneralOrganizational Models and Information Systems.- Seamless Integration of ABC Unified...
View full detailsAdvances in Geoscience and Remote Sensing Technology: Proceedings of the 2nd IC-Georest, October 26-27, 2024, Padang, Indonesia
Joshapat Tetuko Sri Sumantyo, Pakhrur Razi
Hardcover
• Author(s): Joshapat Tetuko Sri Sumantyo | Pakhrur Razi • Publisher: Springer • Publisher Imprint: Springer • BISAC: Physics - Geophysics.- Review of long term patterns of nighttime VIIRS detections of lights, boats and offshore lights, fires, a...
View full detailsMicrobial Biotechnology in Textile Innovation
Mohsin Khurshid, Muhammad Aamer Mehmood, Muhammad Kashif
Hardcover
• Author(s): Mohsin Khurshid | Muhammad Aamer Mehmood | Muhammad Kashif • Publisher: Springer • Publisher Imprint: Springer • BISAC: Materials Science - GeneralChapter 1. Microbial Biotechnology in Textile Industry: An Introduction.- Chapter 2. M...
View full detailsKnowledge Science, Engineering and Management: 18th International Conference, Ksem 2025, Macao, China, August 4-7, 2025, Proceedings, Part I
Tianqing Zhu, Wanlei Zhou, Congcong Zhu
Paperback
• Author(s): Tianqing Zhu | Wanlei Zhou | Congcong Zhu • Publisher: Springer • Publisher Imprint: Springer • BISAC: Artificial Intelligence - GeneralThe six-volume proceedings set LNAI 15919, 15920, 15921, 15922, 15923 and 15924 constitutes the r...
View full detailsNeural Information Processing: 32nd International Conference, Iconip 2025, Okinawa, Japan, November 20-24, 2025, Proceedings, Part VI
Tadahiro Taniguchi, Chi Sing Andrew Leung, Tadashi Kozuno
Paperback
• Author(s): Tadahiro Taniguchi | Chi Sing Andrew Leung | Tadashi Kozuno • Publisher: Springer • Publisher Imprint: Springer • BISAC: Databases - Data MiningThis 6-volume set constitutes the proceedings of the 32nd International Conference on Neu...
View full detailsNatural Language Processing and Chinese Computing: 14th National Ccf Conference, Nlpcc 2025, Urumqi, China, August 7-9, 2025, Proceedings, Part IV
Xian-Ling Mao, Zhaochun Ren, Muyun Yang
Paperback
• Author(s): Xian-Ling Mao | Zhaochun Ren | Muyun Yang • Publisher: Springer • Publisher Imprint: Springer • BISAC: Artificial Intelligence - GeneralThe four-volume set LNAI 16102 - 16105 constitutes the refereed proceedings of the 14th CCF Natio...
View full detailsReliability, Safety, and Security of Railway Systems. Modelling, Analysis, Verification, and Certification: 6th International Conference, Rssrail 2025
Maurice H. Ter Beek, Simon Collart-Dutilleul, Thierry Lecomte
Paperback
• Author(s): Maurice H. Ter Beek | Simon Collart-Dutilleul | Thierry Lecomte • Publisher: Springer • Publisher Imprint: Springer • BISAC: Hardware - GeneralThis book constitutes the proceedings of the 6th International Conference, RSSRail 2025, i...
View full detailsInformation and Cyber Security: 23rd International Conference, Issa 2024, Gqeberha, South Africa, December 2-3, 2024, Revised Selected Papers
Hein Venter, Mariki Eloff, Jan Eloff
Paperback
• Author(s): Hein Venter | Mariki Eloff | Jan Eloff • Publisher: Springer • Publisher Imprint: Springer • BISAC: Security - CryptographyThis book constitutes the refereed post-conference proceedings of the 23rd International Conference on Informa...
View full detailsIntegrated Formal Methods: 20th International Conference, Ifm 2025, Paris, France, November 19-21, 2025, Proceedings
Ferruccio Damiani, Marie Farrell
Paperback
• Author(s): Ferruccio Damiani | Marie Farrell • Publisher: Springer • Publisher Imprint: Springer • BISAC: Software Development & Engineering - GeneralThis book constitutes the refereed proceedings of the 20th International Conference on Int...
View full detailsSecurity and Cryptography: 20th International Conference, Secrypt 2023, Rome, Italy, July 10-12, 2023, and 21st International Conference, Secrypt 2024
Pierangela Samarati, Sabrina de Capitani Di Vimercati
Paperback
• Author(s): Pierangela Samarati | Sabrina de Capitani Di Vimercati • Publisher: Springer • Publisher Imprint: Springer • BISAC: Networking - GeneralThis book includes extended and revised versions of a set of selected papers presented at the 20t...
View full detailsDigital Economy. Emerging Technologies and Business Innovation: 10th International Conference on Digital Economy, Icdec 2025, Tunis, Tunisia, May 15-1
Rim Jallouli, Mohamed Anis Bach Tobji, Nessrine Omrani
Paperback
• Author(s): Rim Jallouli | Mohamed Anis Bach Tobji | Nessrine Omrani • Publisher: Springer • Publisher Imprint: Springer • BISAC: Electronic Commerce
Emotions in Cross-Cultural Psychology: A Curated Literature Overview
Thu Trang Vu, Dung Vu, Thi Mai Lan Nguyen
Paperback
• Author(s): Thu Trang Vu | Dung Vu | Thi Mai Lan Nguyen • Publisher: Springer • Publisher Imprint: Springer • BISAC: Social Psychology
Ai-Enabled Uav-Assisted Massive Mimo: Relaying for 5g-And-Beyond Wireless Networks
Tho Le-Ngoc, Mohammadmahdi Ghadaksaz, Mobeen Mahmood
Hardcover
• Author(s): Tho Le-Ngoc | Mohammadmahdi Ghadaksaz | Mobeen Mahmood • Publisher: Springer • Publisher Imprint: Springer • BISAC: Networking - General
Intelligent Systems, Blockchain, and Communication Technologies: Selected Papers from the 2nd International Conference on Intelligent Systems, Blockch
Ahmed Abdelgawad, Alaa Ali Hameed, Akhtar Jamil
Paperback
• Author(s): Ahmed Abdelgawad | Alaa Ali Hameed | Akhtar Jamil • Publisher: Springer • Publisher Imprint: Springer • BISAC: Artificial Intelligence - GeneralThis book presents peer-reviewed research from ISBCom 2025 that bridges intelligent syste...
View full detailsThe Golgi Network, Volume I: Golgi Organization and Dynamics
Akihiko Nakano, Jaakko Saraste
Hardcover
• Author(s): Akihiko Nakano | Jaakko Saraste • Publisher: Springer • Publisher Imprint: Springer • BISAC: Life Sciences - Cell Biology
Engineering and Management of Data Science, Analytics, and Ai/ML Projects: Foundations, Models, Frameworks, Architectures, Standards, Processes, Pract
Manuel Mora, Jorge Marx Gómez, Fen Wang
Hardcover
• Author(s): Manuel Mora | Jorge Marx Gómez | Fen Wang • Publisher: Springer • Publisher Imprint: Springer • BISAC: Data Science - GeneralThis book presents a dual perspective on modern research and praxis on Data Science, Analytics, and AI/Machi...
View full detailsBusiness Entrepreneurship and Innovation: The Advocacy for a Tech-Corporate Ecosystem
Samer Ajour El Zein, Chelo Morillo
Hardcover
• Author(s): Samer Ajour El Zein | Chelo Morillo • Publisher: Springer • Publisher Imprint: Springer • BISAC: Development - Economic Development
Infectious Diseases and Arthropods
Jerome Goddard
Hardcover
• Author(s): Jerome Goddard • Publisher: Springer • Publisher Imprint: Springer • BISAC: Microbiology
Handbook of the Effects of Landfill Emissions on Sustainable Development
Abdelkader Anouzla, Salah Souabi, Tonni Agustiono Kurniawan
Hardcover
• Author(s): Abdelkader Anouzla | Salah Souabi | Tonni Agustiono Kurniawan • Publisher: Springer • Publisher Imprint: Springer • BISAC: Environmental - Pollution ControlThis book describes landfill sites, (designated areas for the disposal of was...
View full detailsHere Comes the Sign: The Semiotics of Popular Music
Dario Martinelli
Hardcover
• Author(s): Dario Martinelli • Publisher: Springer • Publisher Imprint: Springer • BISAC: Semiotics & TheoryThis text is an original and unique introduction to musical semiotics through the use of popular music acts and repertoires of global...
View full detailsHigh-Performance Textile Composites: Characteristics and Applications
Anurag Dixit, Pawan Sharma, Harlal Singh Mali
Hardcover
• Author(s): Anurag Dixit | Pawan Sharma | Harlal Singh Mali • Publisher: Springer • Publisher Imprint: Springer • BISAC: Materials Science - GeneralThis edited book provides an in-depth overview of high-performance textile reinforcements and com...
View full detailsResearch on E-Learning and ICT in Education: Technological, Pedagogical and Instructional Perspectives
Ioannis Kazanidis, Avgoustos Tsinakos
Hardcover
• Author(s): Ioannis Kazanidis | Avgoustos Tsinakos • Publisher: Springer • Publisher Imprint: Springer • BISAC: Schools - Levels - Higher
Intelligent Logistics Management in Digital Economy: Theories and Methods
Feng Yang, Xiaolong Guo, Yugang Yu
Hardcover
• Author(s): Feng Yang | Xiaolong Guo | Yugang Yu • Publisher: Springer • Publisher Imprint: Springer • BISAC: Production & Operations ManagementThis book delivers a systematic study of intelligent logistics management in the context of the d...
View full detailsPraxishandbuch Ressourcenorientiertes Lerncoaching: Grundlagen, Haltung, Methoden Und Beispiele in Einem Integrativen Rahmenmodell
Volker Biesel
Hardcover
• Author(s): Volker Biesel • Publisher: Springer • Publisher Imprint: Springer • BISAC: Educational Psychology
Integrative Ernährung: Ein Ganzheitliches Konzept Zur Prävention Und Ernährungstherapie
Claudia Nichterl
Paperback
• Author(s): Claudia Nichterl • Publisher: Springer • Publisher Imprint: Springer • BISAC: Alternative & Complementary Medicine
Proceedings of the Canadian Society for Civil Engineering Annual Conference 2024, Volume 3: Engineering Management
Pouya Zangeneh, Farnaz Sadeghpour, Clare Robinson
Hardcover
• Author(s): Pouya Zangeneh | Farnaz Sadeghpour | Clare Robinson • Publisher: Springer • Publisher Imprint: Springer • BISAC: Construction - Heating, Ventilation & Air ConditioningThis book comprises the proceedings of the Annual Conference o...
View full detailsOnline Misogyny in Brazil: Law, Internet Governance, and the Struggle for Gender Justice
Mariana Valente
Hardcover
• Author(s): Mariana Valente • Publisher: Springer • Publisher Imprint: Springer • BISAC: Gender Studies
Diasporas, Voting and Linguistic Justice: A Study of Second- And Third-Generation Italo-Australians
Matteo Bonotti, Chiara de Lazzari, Narelle Miragliotta
Hardcover
• Author(s): Matteo Bonotti | Chiara de Lazzari | Narelle Miragliotta • Publisher: Springer • Publisher Imprint: Springer • BISAC: Emigration & Immigration
Artificial Intelligence Over Infrared Images for Medical Applications: 4th International Conference, Aiiima 2025, Virtual Event, November 15, 2025, Pr
Siva Teja Kakileti, Geetha Manjunath, Robert G. Schwartz
Paperback
• Author(s): Siva Teja Kakileti | Geetha Manjunath | Robert G. Schwartz • Publisher: Springer • Publisher Imprint: Springer • BISAC: Artificial Intelligence - Computer Vision & Pattern RecognitThis book constitutes the refereed proceedings of...
View full detailsKnowledge in the World: Epistemic Vulnerability, Verisimilitude, and Truth
Óscar L. González-Castán
Hardcover
• Author(s): Óscar L. González-Castán • Publisher: Springer • Publisher Imprint: Springer • BISAC: EpistemologyThis book proposes a new set of concepts in epistemology and philosophy of science and provides a novel account of theory change using ...
View full detailsInvestment Protection and Environmental Governance: The Eu-Vietnam IPA in Light of Emerging Economies
Nguyen Thi Lan Huong
Hardcover
• Author(s): Nguyen Thi Lan Huong • Publisher: Springer • Publisher Imprint: Springer • BISAC: InternationalThis book explores key innovations in the EU-Vietnam Investment Protection Agreement that shape Vietnam's ability to regulate for environm...
View full detailsPolitical Authority: The Paradox and Promise of Constructivism in Politics
Michael Buckley
Hardcover
• Author(s): Michael Buckley • Publisher: Springer • Publisher Imprint: Springer • BISAC: PoliticalThis book defends constructivism as a leading approach to formulating the moral basis of political authority. It addresses a central tension in con...
View full detailsFungal Additives and Bioactives in Food Processing Industries: Challenges and Prospects
Bhim Pratap Singh, Shekhar Agnihotri, Harinder Singh Oberoi
Hardcover
• Author(s): Bhim Pratap Singh | Shekhar Agnihotri | Harinder Singh Oberoi • Publisher: Springer • Publisher Imprint: Springer • BISAC: Life Sciences - Mycology"Fungal Additives and Bioactives in Food Processing Industries: Challenges and Prospec...
View full detailsIndigenous Peoples in the World Bank Group's Practice: An Inquiry in Light of International Human Rights Law
Silvia Solidoro
Hardcover
• Author(s): Silvia Solidoro • Publisher: Springer • Publisher Imprint: Springer • BISAC: InternationalThis book explores whether the World Bank Group, despite not being formally bound by international human rights law, operates in accordance wit...
View full detailsSmart Nanomaterials in Biomedical Applications: Properties and Functional Behaviors
Safaa Najah Saud Al-Humairi, Abdollah Bahador, Nida Iqbal
Hardcover
• Author(s): Safaa Najah Saud Al-Humairi | Abdollah Bahador | Nida Iqbal • Publisher: Springer • Publisher Imprint: Springer • BISAC: Applied SciencesHarnessing the Potential of Smart Nanomaterials Addressing Healthcare Challenges through Advance...
View full detailsSustainable Technologies for Transforming Businesses and Societies: The Keynote Lectures of the 6th International Conference on Entrepreneurship, Inno
Balvinder Shukla, K. M. Soni, Nitasha Hasteer
Hardcover
• Author(s): Balvinder Shukla | K. M. Soni | Nitasha Hasteer • Publisher: Springer • Publisher Imprint: Springer • BISAC: Artificial Intelligence - GeneralThis edited volume is a compilation of peer-reviewed papers from the plenary lectures, keyn...
View full detailsCybersecurity Governance: An Enterprise Risk Management Strategy for Cyber Risk Control
Kok Boon Oh, Giang Hoang, John Sturdy
Hardcover
• Author(s): Kok Boon Oh | Giang Hoang | John Sturdy • Publisher: Springer • Publisher Imprint: Springer • BISAC: Corporate Governance
Knowledge Science, Engineering and Management: 18th International Conference, Ksem 2025, Macao, China, August 4-7, 2025, Proceedings, Part IV
Tianqing Zhu, Wanlei Zhou, Congcong Zhu
Paperback
• Author(s): Tianqing Zhu | Wanlei Zhou | Congcong Zhu • Publisher: Springer • Publisher Imprint: Springer • BISAC: Artificial Intelligence - GeneralThe six-volume proceedings set LNAI 15919, 15920, 15921, 15922, 15923 and 15924 constitutes the r...
View full detailsBioactive Proteins and Peptides from Marine Shellfish
Ming Du, Shuzhen Cheng
Hardcover
• Author(s): Ming Du | Shuzhen Cheng • Publisher: Springer • Publisher Imprint: Springer • BISAC: Food Science - GeneralChapter 1. Introduction.- Chapter 2. Molecular composition and characteristics of marine shellfish protein.- Chapter 3. Digest...
View full detailsPublic History in Japan: Theory and Practice
Masafumi Yokemoto, Miho Hayashi, Michihiro Okamoto
Hardcover
• Author(s): Masafumi Yokemoto | Miho Hayashi | Michihiro Okamoto • Publisher: Springer • Publisher Imprint: Springer • BISAC: HistoriographyThis book explores how public history, a field developing globally, is gaining attention in Japan and bei...
View full detailsTomato Leaf Curl New Delhi Virus (Tolcndv): Insights Into Virome Dynamics and Management
Ravinder Kumar, Rahul Kumar Tiwari, Milan Kumar Lal
Hardcover
• Author(s): Ravinder Kumar | Rahul Kumar Tiwari | Milan Kumar Lal • Publisher: Springer • Publisher Imprint: Springer • BISAC: Life Sciences - Botany
Knowledge Science, Engineering and Management: 18th International Conference, Ksem 2025, Macao, China, August 4-7, 2025, Proceedings, Part II
Tianqing Zhu, Wanlei Zhou, Congcong Zhu
Paperback
• Author(s): Tianqing Zhu | Wanlei Zhou | Congcong Zhu • Publisher: Springer • Publisher Imprint: Springer • BISAC: Artificial Intelligence - GeneralThe six-volume proceedings set LNAI 15919, 15920, 15921, 15922, 15923 and 15924 constitutes the r...
View full detailsCell Biology and Translational Medicine, Volume 27: Role of Stem Cells in Early Development and Aging Related Diseases
Kursad Turksen
Hardcover
• Author(s): Kursad Turksen • Publisher: Springer • Publisher Imprint: Springer • BISAC: Life Sciences - Cell BiologyThis volume in the Cell Biology and Translational Medicine series continues to explore the promising applications of stem cells i...
View full detailsProceedings of the International Symposium on Intelligent Computing and Networking 2025: Isicn 2025
Manuel Rodriguez Martinez, Kejie Lu, Feng Ye
Paperback
• Author(s): Manuel Rodriguez Martinez | Kejie Lu | Feng Ye • Publisher: Springer • Publisher Imprint: Springer • BISAC: Artificial Intelligence - GeneralIntelligent computing and networking are a rapidly growing area that has attracted significa...
View full detailsClimate Resilience: Impact of Quantum Computing and Artificial Intelligence on Urban Planning
Arun Lal Srivastav, Ashutosh Kumar Dubey, Abhishek Kumar
Hardcover
• Author(s): Arun Lal Srivastav | Ashutosh Kumar Dubey | Abhishek Kumar • Publisher: Springer • Publisher Imprint: Springer • BISAC: Electrical
Stabilization, Safety, and Security of Distributed Systems: 27th International Symposium, SSS 2025, Kathmandu, Nepal, October 9-11, 2025, Proceedings
Silvia Bonomi, Partha Sarathi Mandal, Peter Robinson
Paperback
• Author(s): Silvia Bonomi | Partha Sarathi Mandal | Peter Robinson • Publisher: Springer • Publisher Imprint: Springer • BISAC: RoboticsThis book constitutes the proceedings of the 27th International Symposium on Stabilization, Safety, and Secur...
View full detailsEmerging Trends in Information Systems and Technologies: Worldcist 2025 Volume 2
Alvaro Rocha, Hojjat Adeli, Aneta Poniszewska-Marańda
Paperback
• Author(s): Alvaro Rocha | Hojjat Adeli | Aneta Poniszewska-Marańda • Publisher: Springer • Publisher Imprint: Springer • BISAC: Artificial Intelligence - General
Hidden Markov Processes and Adaptive Filtering
Yury A. Kutoyants
Hardcover
• Author(s): Yury A. Kutoyants • Publisher: Springer • Publisher Imprint: Springer • BISAC: Probability & Statistics - Stochastic Processes1 Auxiliary Result.- 2 Small Noise in Both Equations.- 3 Small Noise in Observations.- 4 Hidden Ergodic...
View full detailsChoquet Capacities and Fuzzy Integrals
Gleb Beliakov, Simon James, Jian-Zhang Wu
Hardcover
• Author(s): Gleb Beliakov | Simon James | Jian-Zhang Wu • Publisher: Springer • Publisher Imprint: Springer • BISAC: Computer Science
Navigating the Geodetic Landscape: A Tribute to 45 Years of Excellence: Anniversary Volume on the Occasion of Professor P.J.G.Teunissen's 67th Birthda
Amir Khodabandeh, Sandra Verhagen
Hardcover
• Author(s): Amir Khodabandeh | Sandra Verhagen • Publisher: Springer • Publisher Imprint: Springer • BISAC: Earth Sciences - GeographyReflecting the broad spectrum of Professor Teunissen's research, this Anniversary Volume presents insights into...
View full detailsMultibody Mechatronic Systems: Musme 2025
Mario Acevedo, Leonardo Valdivia, Hiram Ponce
Hardcover
• Author(s): Mario Acevedo | Leonardo Valdivia | Hiram Ponce • Publisher: Springer • Publisher Imprint: Springer • BISAC: MechanicalThis book gathers the latest advances, innovations, and applications in the field of multibody and mechatronic sys...
View full detailsAisma-2025: International Workshop on Advanced Information Security Management and Applications
Maria Lapina, Zahid Raza, Mikhail Babenko
Paperback
• Author(s): Maria Lapina | Zahid Raza | Mikhail Babenko • Publisher: Springer • Publisher Imprint: Springer • BISAC: Data Science - General